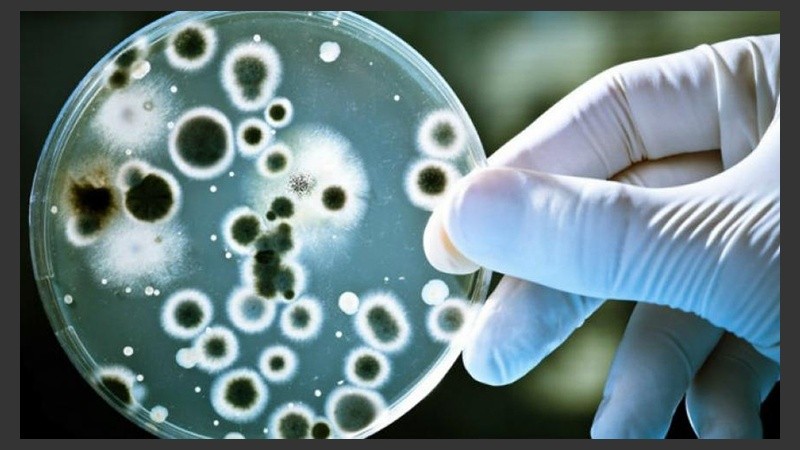
Las bacterias panresistentes pueden soportar todo tipo de antibióticos.

Europa está en alerta por la propagación de una bacteria de la especie Acinetobacter baumannii, que logró resistencia a los antibióticos y está asociada a pacientes con neumonía con respiración mecánica. Ya ha matado a 65 personas entre Italia, España y Grecia.
La Acinetobacter baumannii es una causa importante de infecciones hospitalarias, particularmente en los pacientes ingresados en unidades de cuidados intensivos, y en los últimos años ha desarrollado resistencias a antibióticos de primera línea, según un estudio difundido por EFE.
Los investigadores califican a las bacterias según tres tipos de resistencia a los medicamentos: multirresistentes, extensamente resistentes, y panresistentes, las que pueden soportar todo tipo de antibióticos.
De las 65 muestras obtenidas en este caso, una veintena, es decir una de cada tres, se mostraron panresistentes y no detectaron diferencias en las tasas de resistencia entre los tres países.
“La alta incidencia de bacterias aisladas extensamente resistentes y panresistentes subraya la dificultad para encontrar regímenes adecuados para tratar a estos pacientes”, advirtieron los especialistas.